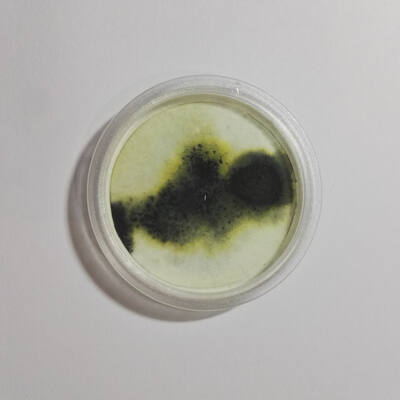
Dissection of unArtist

Trash Poetry, or Trashpo as it is called, is a concept entitled by the fellow artists De Villo Sloan and Jim Leftwich around the year 2005. It intends to be an art form where you will end up re-purposing trash or found objects as supplies for the creation of an art piece. It's a great way to re-purpose all the trash that our planet is buried in! ... it is said.
1) economical
2) environmentally responsible
3) challenging
"If trashpo has taught me anything it’s that every windblown street corner and cyclone fence is a veritable Dick Blick of free art materials."
- DKult Member Meeah Williams
Yet, where to cross the line? When does an object starts being trash? I can support the found objects ideals but when talking about re purposing supposed trash, there comes the harsh definition of the material nature. Can the artist’s own trash be considered as trash even though it might never been seen as so by himself? Won’t trash stop being trash as soon as it is perceived as supplies?
Therefore I propose a different take on the subject, not that it may be more cohesive, but because it is better understandable and in my personal point of view on art it makes more sense.
TRAshART is the result of trashing art. The underlying idea is of creating trash from art in a fashion. It’s more than reverse engineering since the intention is of creating new trash and not of decomposing art into supplies.
LUCity! PACK
assemblage / 148.5 x 210 mmset of 20
2019
refurbished leftovers from Lucity! art installation
REF lucitypack
Tia Graça - toda a gente devia ter uma
mixed media on plywood / 80 x 80 mmset of 10
2017
refurbished leftovers from D’Orfeu’s musical show set design
REF tigraca